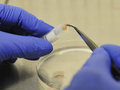
Бесплодие и бездетность — понятия разные

Грибок на ногах
Грибок на ногах




 Косоглазие: глазки врозь и в кучку
Если появилась горошина на веке
Чем опасен просмотр 3D-фильмов
Офтальмологи переходят на "новый уровень"
Как сохранить здоровье глаз надолго
Косоглазие: глазки врозь и в кучку
Если появилась горошина на веке
Чем опасен просмотр 3D-фильмов
Офтальмологи переходят на "новый уровень"
Как сохранить здоровье глаз надолго
 Детский онколог - штучный экземпляр
Врач-онколог, да еще детский, – это штучный экземпляр. Это не менее 10 лет работы по специальности у постели больного. Это особый склад характера. Уровень их подготовки - боль и беда нашего здравоохранения. Об этом шла речь на "круглом столе", посвященном вопросам "бюджетного маневра" в здравоохранении. По этому поводу высказались эксперты.
Детский онколог - штучный экземпляр
Врач-онколог, да еще детский, – это штучный экземпляр. Это не менее 10 лет работы по специальности у постели больного. Это особый склад характера. Уровень их подготовки - боль и беда нашего здравоохранения. Об этом шла речь на "круглом столе", посвященном вопросам "бюджетного маневра" в здравоохранении. По этому поводу высказались эксперты.

| Поговорим о качестве интимной жизни |
| Молодильные яблочки вместо лекарств |